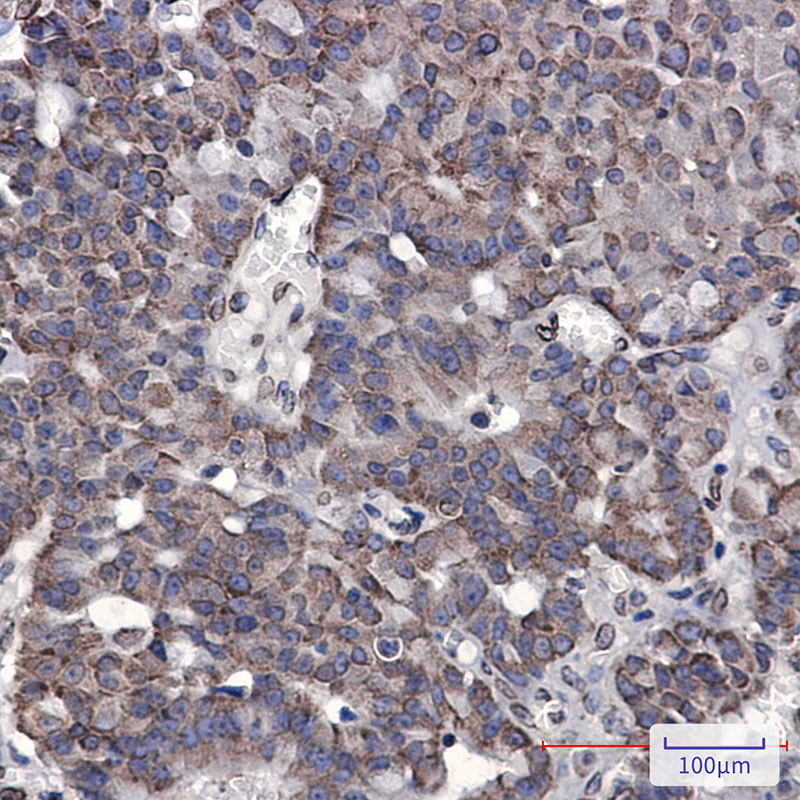

-
分类: 科研抗体货号: P22557别名: RNPL; IS1-RNPL应用: WB,IF反应种属: Human,Mouse
-
分类: 科研抗体货号: P22519别名: Peroxiredoxin-6; Antioxidant protein 2; Liver 2D page spot 40; NSGPx; PRDX6; AOP2; KIAA应用: WB,IP反应种属: Human
-
分类: 科研抗体货号: P22538别名: CDP; CUX; p75; CASP; CDP1; COY1; Clox; GDDI; p100; p110; p200; CUTL1; GOLIM6; CDP/Cut; Cux/CDP; Nbla10317应用: WB,IP,IF反应种属: Human,Mouse,Rat
-
分类: 科研抗体货号: P22556别名: GAP; PKWS; RASA; p120; CMAVM; CM-AVM; CMAVM1; RASGAP; p120GAP; p120RASGAP应用: WB,IHC反应种属: Human
-
分类: 科研抗体货号: P22518别名: PRDX3; AOP1; Thioredoxin-dependent peroxide reductase; mitochondrial; Antioxidant protein 1; AOP-1; HBC189; Peroxiredoxin III; Prx-III; Peroxiredoxin-3; Protein MER5 homolog应用: WB,IP,IHC,IF反应种属: Human
-
分类: 科研抗体货号: P22537别名: PHB1; HEL-215; HEL-S-54e应用: WB,IP,IHC,IF反应种属: Human,Rat
-
分类: 科研抗体货号: P22554别名: RAP80; X2HRIP110应用: WB,IHC,IF反应种属: Human
-
分类: 科研抗体货号: P22517别名: PRDX2; NKEFB; TDPX1; Peroxiredoxin-2; Natural killer cell-enhancing factor B; NKEF-B; PRP; Thiol-specific antioxidant protein; TSA; Thioredoxin peroxidase 1; Thioredoxin-dependent peroxide reductase 1应用: WB,IP反应种属: Human,Mouse,Rat
-
分类: 科研抗体货号: P22535别名: AKT1S1; PRAS40; Proline-rich AKT1 substrate 1; 40 kDa proline-rich AKT substrate应用: WB,IP反应种属: Human,Rat
-
分类: 科研抗体货号: P22553别名: SD; Fug1; RANGAP应用: WB,IP,IHC,IF反应种属: Human,Mouse,Rat

鄂公网安备42018502007531号
鄂公网安备42018502007531号

